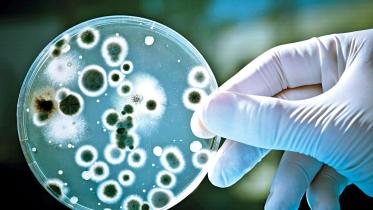

Vitiligo in children may signal hidden risks of hearing loss
18 October 2025, 20:08 PM
Physiotherapy / Post Chikungunya joints and muscle pain management
18 October 2025, 20:08 PM
Food upcycling: The missing link in our fight against food insecurity
18 October 2025, 20:07 PM
New global guidelines target postpartum bleeding to save mothers’ lives
18 October 2025, 20:07 PM
World Anaesthesia Day 2025 / Regional anaesthesia: A safer future for postoperative pain control
18 October 2025, 20:06 PM
Policy Discussion / Tobacco in Bangladesh: Is a safer alternative possible?
18 October 2025, 12:02 PM
Global tobacco use declined, but the epidemic persisted
11 October 2025, 18:06 PM
The five sleep profiles that shape our mental health
11 October 2025, 18:01 PM
Statin use in pregnancy: No increased risk of birth defects
11 October 2025, 18:00 PM
World mental health day 2025: Protecting minds in humanitarian crises
11 October 2025, 18:00 PM
Historic step towards the elimination of cervical cancer
Governments, donors, and global organisations pledged nearly US$600 million in new funding to tackle cervical cancer, marking a historic step towards eliminating the deadly disease cervical cancer.
16 March 2024, 18:00 PM
Rethinking long COVID
New research presented at the European Congress of Clinical Microbiology and Infectious Diseases sheds light on the phenomenon of long COVID, particularly in a highly vaccinated population like Queensland, Australia.
16 March 2024, 18:00 PM
Unlocking the health potential of Ramadan: fasting benefits and nutritional strategies
Since more than 1400 years ago, Muslims have fasted by abstaining from food and drink from dawn to dusk during Ramadan as a must-do task.
16 March 2024, 18:00 PM
Happiness at blue zones
People in these areas live a healthy lifestyle with healthy food habits that promote natural movement through activities such as gardening, walking, cooking, and farming.
9 March 2024, 18:00 PM
Artificial intelligence in improving infection control and responding to and preventing outbreaks
The European Congress of Clinical Microbiology and Infectious Diseases (ECCMID 2024), scheduled to be held in Barcelona from April 27th to April 30th, will feature discussions highlighting the potential of artificial intelligence (AI) in transforming infection control within hospitals.
2 March 2024, 18:00 PM
Celebrating sounds of success
An innovative cultural event was recently held at the super specialised hospital of Bangabandhu Sheikh Mujib Medical University (BSMMU), organised by the Cochlear Implant Group of Bangladesh and the Year Foundation, says a press release.
2 March 2024, 18:00 PM
A lonely killer - Part II
Isolation on an emotional and psychological level is a hallmark of loneliness. Some partners’ inability to respect their partner’s social standing manifests itself in numerous ways. One cause of isolation is treating other people poorly and putting them down.
2 March 2024, 18:00 PM
Not to Stop Here: Inspiring stories of triumph over cancer
The book “Not to Stop Here: Narration by Cancer Survivors” in Bangla, published by the Centre for Cancer Care Foundation (CCCF) Bangladesh and printed by University Press Limited (UPL), contains inspiring stories from 42 cancer survivors, known as the Cancer Bravos.
2 March 2024, 18:00 PM
Facing the global obesity crisis: A call to action for healthier futures
A recent global analysis published in The Lancet reveals a concerning trend: more than one billion people worldwide are now living with obesity, marking it as the most common form of malnutrition in many countries. The NCD Risk Factor Collaboration (NCD-RisC) and the World Health Organisation (WHO) conducted the study, which looked at data from over 220 million people in 190 countries from 1990 to 2022.
2 March 2024, 18:00 PM
A new oral SARS-CoV-2 protease inhibitor for treating COVID-19
Nirmatrelvir/ritonavir (Paxlovid), a SARS-CoV-2 protease inhibitor, is first-line therapy for high-risk, non-hospitalised patients with COVID-19 (JAMA 2023; 330:1519).
10 February 2024, 18:00 PM
A 30-fold rise of measles cases in 2023 warrants urgent action
The World Health Organisation (WHO) European Region is experiencing an alarming rise in measles cases.
10 February 2024, 18:00 PM
Don’t get SAD
Genetics or inheritance are not the causes of every disease. Indeed, external factors like the weather may also have an impact on our general well-being and mood.
10 February 2024, 18:00 PM
WHO awards countries for progress in eliminating industrially produced trans fats for first time
The World Health Organisation (WHO) has awarded its first-ever certificates validating progress in eliminating industrially produced trans fatty-acids to five countries.
10 February 2024, 18:00 PM
Global cancer burden growing, amidst mounting need for services
The World Health Organisation (WHO)’s cancer agency, the International Agency for Research on Cancer (IARC), released the latest estimates of the global burden of cancer.
10 February 2024, 18:00 PM
Video gamers worldwide may be risking irreversible hearing loss
Video gamers worldwide may be risking irreversible hearing loss and/or tinnitus—persistent ringing/buzzing in the ears—finds a systematic review of the available evidence, published in the open access journal BMJ Public Health.
3 February 2024, 18:00 PM
Superiority in a spouse
A lovely relationship starts as gently as the wind. The refrain “I can’t help falling in love with you” appears in a lot of poetry and music. However, maintaining that bond is another story. It is a whole other ballgame to keep the relationship pleasant, especially after marriage.
3 February 2024, 18:00 PM
Metformin decreased dementia risk in older adults with type 2 diabetes mellitus
Type 2 diabetes is a risk factor for dementia. Researchers analysed data from Taiwan’s National Health Insurance Research Database (NHIRD) to assess whether treatment for type 2 diabetes affected dementia risk in adults ≥60 years old with type 2 diabetes mellitus on treatment. Diabetes diagnosis, type of anti-diabetic medication used, and dementia classification were based on NHIRD records.
3 February 2024, 18:00 PM
The roles of microbes in space from a health perspective
The survivability tests of microbes in space conditions started more than 90 years ago. The early experiments utilised balloon flights and rocket payloads to expose the microorganisms in spaceflight conditions. In 1966, the National Aeronautics and Space Administration (NASA) performed experiments on microbes by exposing them to space conditions. The resilience of those organisms was poor due to the radiation of the space.
3 February 2024, 18:00 PM
Perinatal depression linked with long-term suicide risk and all-cause mortality
Perinatal depression, either antenatal (during pregnancy) or postpartum, affects 10% to 20% of pregnant women and is linked with numerous adverse health outcomes. One such outcome, suicide, accounts for as many as 20% of postpartum deaths in high-income countries. In two new studies, researchers used a Swedish dataset to investigate overall mortality and suicidal behavior (attempted or completed suicide) in women with perinatal depression.
3 February 2024, 18:00 PM
Navigating COVID-19 in vulnerable patients: insights from dual antiviral therapy studies in the Omicron era
In managing COVID-19, researchers in Germany have delved into the challenges faced by immunocompromised patients, shedding light on effective strategies during the Omicron era.
20 January 2024, 18:00 PM